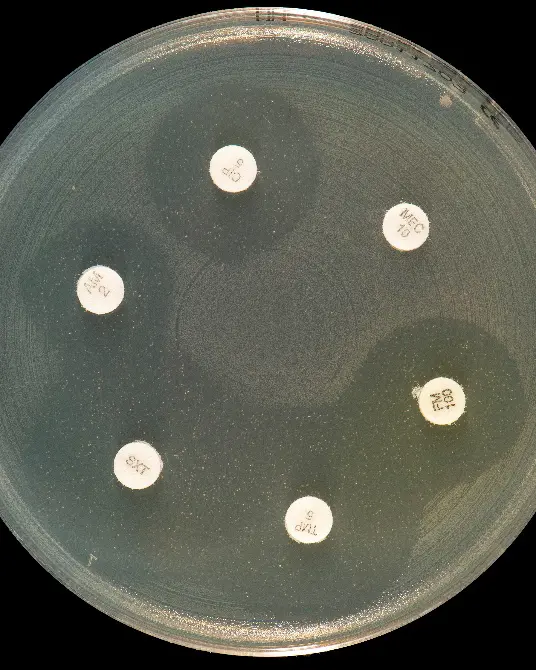
Bilde av bakterie
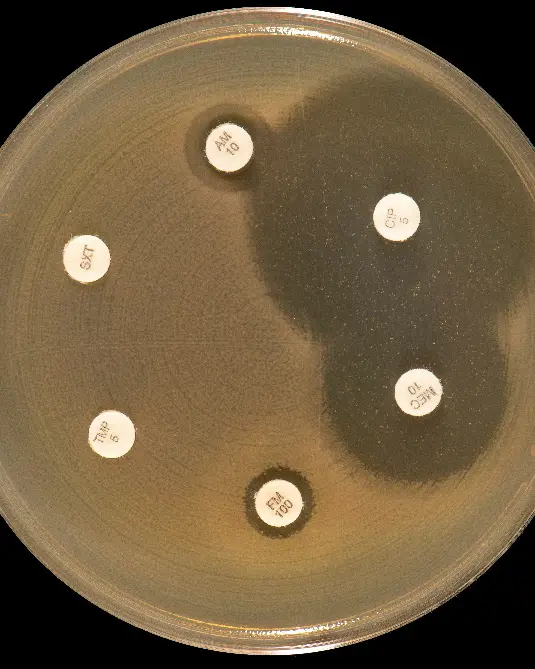
Bilde av bakterie

Ekspertsykehuset
Skreddersydd behandling av infeksjoner
Persontilpasset medisin (også kalt presisjonsmedisin) er en ny æra innenfor medisin hvor vi hele tiden leter etter risikofaktorer for å kunne velge best mulig pasientbehandling. Målet er å forbedre diagnostikken for å kunne velge den optimale behandlingen for den enkelte pasient, også for å unngå at pasienter får behandling som ikke virker. Presisjonsmedisin er super-aktuelt for karakterisering av mennesket og deres mikrober, for å sikre den best mulige behandlingen av infeksjoner.

Tekst av: Tone Tønjum, professor og overlege Avdeling for mikrobiologi UiO/OUS. Nestleder OUS strategisk forskningsområde Turning the Tide of Antimicrobial resistance (TTA). Foto: Øystein Horgmo, Marie Noer, iStock, Tremani.
Hva er en infeksjon?
En infeksjon er smitte med bakterier, virus, sopp eller parasitter. Du kan få en betennelse som reaksjon på en infeksjon. Denne betennelsen er som regel årsaken til symptomene ved infeksjonen.

Tone Tønjum, professor og overlege ved Avd. for mikrobiologi. Foto: Øystein Horgmo.
Utfallet av infeksjonen bestemmes av egenskaper ved mikroben sammen med vertens forsvar mot infeksjoner, påvirket av antimikrobiell og annen behandling. Siden både mikrobe og vert er vesentlige for infeksjonsutviklingen, bør de begge kartlegges for at vi skal kunne servere presisjonsmedisin i infeksjonsmedisinen.
Betydningen av DNA-sekvensering i infeksjonsmedisin
DNA er en forkortelse for deoksyribonukleinsyre, som er den viktigste kjemiske bestanddelen i kromosomene, og materialet som alle gener er bygget opp av. (Fig. 1).
DNA er et kjemisk stoff som finnes i alle celler og i mange virus, og har to grunnleggende funksjoner: DNA bestemmer cellens egenskaper ved at det dirigerer oppbyggingen av alle proteiner, og deretter overfører disse egenskapene som arveanlegg til cellens avkom når cellen deler seg.
Neste generasjons DNA-sekvensering (NGS) er bestemmelse av arvematerialets sammensetning i stor skala. For eksempel har gen-sekvensering revolusjonert daglig mikrobiologisk praksis ved å avsløre det bemerkelsesverdige mangfoldet, sammensetningen og identiteten til bakteriesamfunn som er forbundet med mennesker og dyr.
Videre kan hele arvematerialet (genomet) i en celle karakteriseres. Derved kan en større helhet hos både den infiserende mikroben og pasienten bli kjent og bruke i diagnostikk.
Genomsekvenser er en gullgruve for å forstå infeksjoner og samspillet mellom mikrobe og vert og har gjennom en årrekke blitt utført gjennom masse-genomsekvensering (genomikk). Derved har viktig ny kunnskap blitt sikret, som en god forutsetning for videre utvikling av presisjonsmedisinen.
Neste nivå: Molekyler er dekorert
Nyere studier viser imidlertid at store molekyler som DNA, RNA og proteiner er "pyntet" med komplekse kjemiske signatur-motiver. Disse dekorasjonene kan ikke påvises ved konvensjonelle genomiske / NGS-metoder og konvensjonelle molekylære tester. Derfor utvikler vi nye metoder som kan påvise hvordan basismolekylene er «pyntet».
Ved såkalt Oxford Nanopore-sekvensering kan dekorasjon av DNA og RNA påvises (1), mens ved massespektrometri kan dekorasjoner på proteiner (såkalt post-translasjonelle modifikasjoner, PTM) påvises (2).
Antibiotika og infeksjoner
Antibiotika kan hemme bakteriers vekst, og i mange tilfelle også drepe bakterien. Et godt antibiotikum hemmer eller dreper bakteriene når de blir eksponert for konsentrasjon er som er giftige for bakteriene, men ikke er farlige for verten (mennesket eller dyr) som har en infeksjon.
Antimikrobiell resistens er økende
Antimikrobiell resistens (AMR) er en raskt økende global helsekrise, knyttet til at bare et redusert antall effektive medisiner virker mot mikrober (bakterier, virus, sopp og parasitter). Dette scenariet og mangelen på beredskap gjør at det haster med å finne nye antimikrobielle stoffer.
De økonomiske kostnadene ved AMR-pandemien tilsvarer milliarder av Euro årlig, og samfunnskostnadene er umåtelige. Tallrike mikrobielle endringer i arvestoffet med DNA-mutasjoner og horisontale genoverføringshendelser forårsaker direkte eller bidrar til AMR, og har blitt grundig karakterisert ved NGS.
Nyere studier viser imidlertid at AMR ofte påvirkes av de komplekse kjemiske endringene av DNA, RNA og protein nevnt ovenfor, som ikke kan påvises ved konvensjonelle genomiske tilnærminger. (1.2) Disse antibiotikaresistente variantene «epitypene», knyttet til spesifikke pynte-signaturer på molekyler, har ikke påvisbare genetiske endringer, utvikler seg raskt under selektivt trykk og kan være forbigående og reversible.
Derved er det nye kunnskapshull å fylle i presisjonsmedisinen, for å sikre effektiv behandling av infeksjoner. Disse kunnskapshullene fokuserer forskningsnettet Turning the Tide of Antimicrobial resistance (TTA) på i sin forskning. Samtidig adresserer TTA det faktum at behovet for nye antibiotika er enormt (Fig 2).

Fig.2. Strømlinjeforming av små molekyler testes som kandidater for ny antibiotikabehandling. Foto: Tremani.
Resistensbestemmelse av bakterier
Selv om NGS og makromolekylær modifikasjon sier mye om AMR, er fortsatt fenotypisk resistensbestemmelse (påvisning ved dyrkning i laboratoriet) som gjelder for bakterier (Fig. 3). Ved resistensbestemmelse ved måling av sone for bakterievekst/hemming rundt en antibiotkalapp ved agardiffusjon, kan vi se i laboratoriet om en gitt bakterie er følsom eller resistent for et gitt antibiotikum (Fig. 3A). Dessverre blir stadig flere bakterier resistente (Fig. 3B).

Hvorfor blir noen syke, og ikke andre?
Dagens kunnskap gir utsikter for en skreddersydd medsin som er tilpasset den enkelte pasient som har en infeksjon. Strømlinjeformet behandling av infeksjoner fordrer at vi har kunnskap om mikroben (resistensbestemmelse), verten (aktuell status og genetisk predisposisjon) og gode medisiner (effektiv antimikrobiell behandling, som kan måles i pasienten ved farmakometri).
Vi stiller ofte spørsmålet om hvorfor noen blir sykere enn andre, og hva vi kan gjøre for å forstå hva som ligger til grunn for dette. Mange forhold påvirker menneskets predisposisjon for å få en infeksjon, ikke minst immunforsvaret.
Vi er vant til å tenke oss at det er ytre omstendigheter som er grunnlag for at man er disponert for sykdom, for eksempel et hardt liv, stress, sorg eller lignende. Men svaret ligger vel så mye i arvematerialet vårt og hvordan våre molekyler er dekorert, inkludert komponentene i immunforsvaret, enn i ytre omstendigheter.
For eksempel blir arvematerialet (DNA) i kroppene våre og i mikrober, ødelagt hele livet, av for eksempel indre stress fra stoffskiftet i cellene, eller ytre påvirkninger som stråling, forurensning, sol, røyking og annen forurensning. Derfor er vi avhengig av at DNAet repareres hele tiden. Disse DNA-reparasjonsmolekylene er også dekorert. Hos noen personer er det en defekt i DNA-reparasjonen som gir predisposisjon for infeksjon hos andre en variant i molekyl-dekorasjon.
For å forstå predisponering for infeksjoner, må man forstå hvordan molekylene i kroppen fungerer sammen. Siden «nøkkelen til det gode liv ligger i molekylene», forsker TTA på både arvematerialet vårt og hvordan molekyler er dekorert, såkalt "epi-omikk".
Strømlinjeformet behandling
Utgangspunkt for forskningen i presisjonsmedisin er menneskenes ønske om et langt liv og en god alderdom med høy livskvalitet i livets siste år. I dag brukes som regel samme type medisin mot de samme sykdommene, uavhengig av individuelle forskjeller hos personene. Det kan vi gjøre noe med via presisjonsmedisin.
Det er allerede mulig for enhver å få kartlagt DNA-profilen sin (for eksempel "23 and me"), og vi tror dette vil bli rutine i fremtiden. Nå vil vi trekke denne trenden videre.
Forskningen ved TTA på epi-omikk er neste steg på veien mot et nytt nivå på skreddersydd medisinsk diagnostikk og behandling. Det hadde jo vært fint med en medisinsk cocktail tilpasset vårt arvemateriale og status, som sikrer god helse og behandling. Vi forskere ved Oslo universitetssykehus ønsker derfor å være «din medisinske bartender».
Veien videre
Effektiv presisjonsmedisin for infeksjoner vil kreve et løft innen klinisk utprøving og teknologi herunder datafangst, datalagring og analyseverktøy. Vi trenger økt kompetanse på bioinformatikk, statistikk, maskinlæring og kunstig intelligens for at fullgod behandling innen infeksjoner skal kunne oppnås.
Det er i denne sammenheng vesentlig at helsepersonell, pasienter, forskere og politikere står sammen og tar AMR-problematikken rundt antibiotikaresistens i norsk helsevesen på alvor. TTA-nettverket adresserer derved vesentlige aspektrer innen presisjonsmedisinen.
Lenker til nettsider:
Forskningsnettverket Turning the Tide of Antimicrobial resistance (TTA) ved OUS og UiO (TTA).
Les mer om professor og forsker Tone Tønjum.
Referanser:
1. Ghosh, D., B. Veeraraghavan, R. Elangovan and P. Vivekanandan, Antibiotic Resistance and Epigenetics: More to It than Meets the Eye. Antimicrob Agents Chemother, 2020. 64(2).
2. Birhanu, A.G., S.A. Yimer, S. Kalayou, T. Riaz, E.D. Zegeye, and T. Tonjum, Ample glycosylation in membrane and cell envelope proteins may explain the phenotypic diversity and virulence in the Mycobacterium tuberculosis complex. Sci Rep, 2019. 9(1): p. 2927.
Les mer om antibiotikaresistens og forskningen ved Oslo universitetssykehus.
Les flere blogginnlegg fra Ekspertsykehuset her!